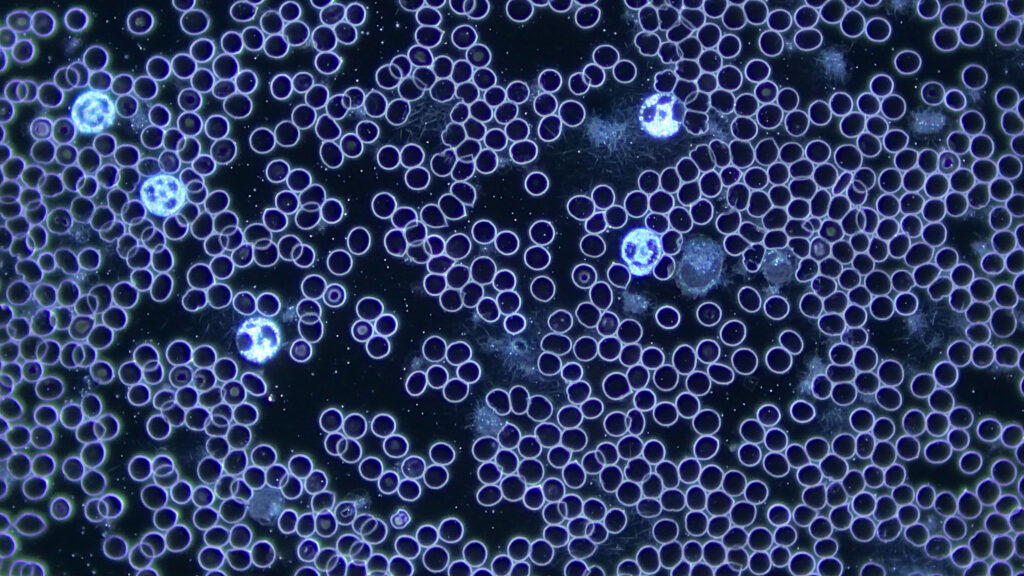

„Das Blut wie ein funkelnder Sternenhimmel: Unter dem Dunkelfeldmikroskop offenbart sich das Blut wie ein lebendiger Kosmos, dessen Milieu unsere Gesundheit spiegelt.“
Wie verläuft die Vitalblutanalyse?
Es steht Ihnen frei, ob Sie gerne persönlich in die Praxis kommen möchten, um Ihr Blut selber zu sehen und erklärt zu bekommen oder ob Sie es lieber per Post einschicken
Der Termin vor Ort beinhaltet:
- Anamnesegespräch
- Blutabnahme, gemeinsame Betrachtung unter dem Dunkelfeldmikroskop mit Erklärung
- Weitere Auswertung des Blutes in den Folgetagen und radionische Testung auf über 110 Parameter
- Ausführliche Befundbesprechung und Erklärung des Therapieplans vor Ort oder per Zoom (je nach Wunsch)
Kosten 295 € zum Ersttermin
Die postalische Blutanalyse beinhaltet:
- Zusendung des Anamnesebogens und eines Testsets zur Blutentnahme
- Bei Eintreffen der Blutprobe im Institut Untersuchung unter dem Dunkelfeldmikroskop je nach Lebensdauer
- Radionische Analyse auf über 110 Parameter
- Ausführliche Befundbesprechung und Erklärung des Therapieplans per Zoom
Kosten 255 €

Wie arbeiten wir im Institut für Selbstheilung?
Im Institut für Selbstheilung arbeiten Kathrin Meerle Mayer und ich nach der Methode von HP Ekkehard Sirian Scheller (1943-2015). Dank dieses ganzheitlichen Diagnoseverfahrens, das die Dunkelfeldnikroskopie von Prof. Dr. Enderlein mit der Radionik von Bruce Copen verbindet, ist es uns möglich, viele der Ursachen Ihrer Beschwerden zu erkennen. Die Behandlung verläuft in fünf aufeinander abgestimmten Schritten:
1. Anamnese & Probenahme
Bei unserem ersten Termin führen wir zunächst ein Gespräch über Ihre aktuelle gesundheitliche Situation. Anschließend entnehmen wir mit einer feinen Lanzette ein paar Tropfen Blut aus Ihrer Fingerbeere und gebe sie auf einen Objektträger. Da das Blut weder fixiert noch gefärbt wird, bleibt es in seinem natürlichen, lebendigen Zustand.
2. Direkter Blick in Ihr Blut
Gleich nach der Entnahme betrachten wir Ihr Blut gemeinsam mittels Videoübertragung unter einem Zeiss® Axio Lab 5 Dunkelfeldmikroskop. Dabei können wir erste Aussagen über Ihre Zellgesundheit, Ihr Blutmilieu und Ihren Allgemeinzustand machen.
3. Langzeitbeobachtung
Wir beobachten Ihre Blutprobe über mehrere Tage hinweg bis zum natürlichen Zerfall. Dies hat den Grund, dass manche Zellbelastungen erst im Laufe der Zeit zum Vorschein kommen.
4. Radionische Testung nach Bruce Copen
Als perfekte Ergänzung zur mikroskopischen Analyse erfolgt die radionische Testung von ca. 110 verschiedenen Parametern. Da das Blut mit Ihrem morphogenetischen Feld verbunden ist, können wir anhand dieser Testung Aussagen über Ihr gesamtes System treffen. So ist es möglich, gesundheitsbelastende Faktoren zu ermitteln und besser zu verstehen, welche Ursachen Ihren Beschwerden zugrunde liegen.
5. Befundbericht & individuelle Therapie
Bei unserem zweiten Termin besprechen wir ausführlich Ihren Befundbericht und den dazugehörigen Therapieplan. Im Zentrum Ihrer Behandlung steht dabei die Erstellung Ihrer persönlichen Infoessenz® nach Kathrin Meerle Mayer. Diese Informationsrezeptur ist darauf ausgerichtet, Ihre Selbstheilungskräfte durch Symbiontenaktivität anzuregen und Ihren Organismus sanft in die Regulation zurückzuführen.



Anwendungsgebiete der Vitalblutanalyse – Wann kann Ihnen die Vitalblutanalyse weiterhelfen?
Eine Vitalblutanalyse kann wertvolle Erkenntnisse liefern und Lösungsansätze aufzeigen bei:
- Neurologischen, autoimmunen, psychischen und onkologischen Erkrankungen
- Chronischen und entzündlichen Erkrankungen
- Immunschwäche und hoher Infektanfälligkeit
- Borreliose, Gelenkschmerzen und Neuralgien
- Post-Vac-Syndrom, chronischer Müdigkeit (CFS), Antriebslosigkeit
- Verdauungsbeschwerden und Lebensmittelunverträglichkeiten
- Allergien und Mastzellaktivierungssyndrom (MCAS)
- Befall durch Parasiten oder Candida
- Bedarf an Ausleitung und Entgiftung
- Kryptopyrrolurie (KPU/HPU) sowie Mitochondriopathie

Wenn Sie mehr über die Vitalblutanalyse, Dunkelfeldmikroskopie, Radionik und Infoessenzen nach Kathrin Meerle Mayer erfahren möchten, werfen Sie doch gerne einen Blick auf die Seite des Instituts für Selbstheilung
Wichtiger Hinweis: Die Dunkelfeldmikroskopie ist ein naturheilkundliches Verfahren. Die genannten Anwendungsgebiete basieren auf therapeutischer Erfahrung und sind wissenschaftlich nicht im Sinne der Schulmedizin belegt.
